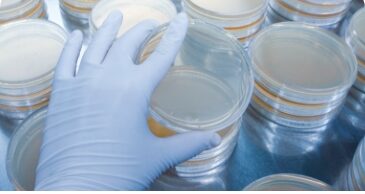

Prof Andrew Bradley and QMMS are heavily involved in research projects both in the U.K. and overseas and have published widely within the area of udder health and mastitis control. These papers cover such areas as prevention of mastitis, the use of dry cow therapy, treatment of persistently infected high somatic cell count cows and product studies for large multinational companies. Our partners have involved the Universities of Bristol, Nottingham and Warwick, companies such as Pfizer Animal Health, Intervet, Boehringer Ingelheim, Leo Animal Health and DeLaval, and industry bodies such as DairyCo/AHDB. More recently we have collaborated with computing and technical companies including AnalyticEye and GRID-IMP.
Many of these papers undergo ‘peer-review’ (i.e. they are read and commented on by other veterinary surgeons and academics in the relevant fields) before publication in highly ranked journals such as the Journal of Dairy Science and The Veterinary Record. Other publications are written for various national and international conferences and present the latest thinking in udder health, and other topics relevant to dairy farmers.
This allows QMMS to maintain a ‘cutting edge’, impartial service based on the latest scientific evidence.
Links are given to the full papers where these are “Open Access”. To request copies of other papers, please contact QMMS.